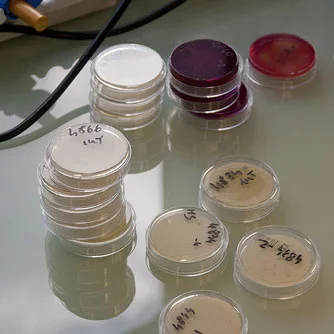
campionamento enterococco per idoneità balneazione

Balneazione – Cosa fa ARPAT
Temi ambientali:
Balneazione
ARPAT è l’ente che, in Toscana, svolge le attività tecnico-scientifiche a supporto dei compiti istituzionali di Stato, Regione e Comuni in materia di balneazione.
Le attività sono quelle dettagliate nella Carta dei Servizi; In particolare ARPAT
- offre supporto tecnico alla Regione per l’individuazione, la delimitazione e la classificazione delle aree di balneazione;
- nel periodo che va dal 1 aprile al 30 settembre di ciascun anno effettua il monitoraggio delle acque di balneazione, garantendo il campionamento e l’esecuzione delle analisi, al fine di verificare il rispetto dei limiti previsti dalla normativa e quindi l’idoneità alla balneazione;
- trasmette i dati relativi al monitoraggio al Ministero, garantendone gli standard e i requisiti necessari all’implementazione della rete dati e all’elaborazione della reportistica nazionale ed europea sulla balneazione;
- in caso di superamento dei limiti di legge ne dà immediata comunicazione ai Comuni interessati affinchè questi, con ordinanza del Sindaco, adottino i divieti temporanei di balneazione e appongano intorno all’area segnaletica idonea a far conoscere il divieto ai bagnanti. Contemporaneamente ARPAT predispone i campionamenti suppletivi finalizzati alla revoca del divieto;
- sorveglia le aree su cui insistono divieti permanenti per motivo igienico-sanitari, effettuando campionamenti e analisi al fine di valutarne lo stato e il risanamento;
- da fine giugno a settembre effettua il monitoraggio dell’alga tossica Ostreopsis Ovata nei punti di campionamento individuati dalla Regione;
- a fine stagione elabora un report annuale con il quale si sintetizza l’attività svolta e l’andamento della stagione;
- attua una capillare azione di informazione nei confronti del pubblico pubblicando immediatamente sul proprio sito web i risultati del monitoraggio e fornendo informazioni sui fenomeni di inquinamento temporaneo anche attraverso X (ex Twitter) con l’hashtag #balneazione. Per favorire la consultazione dei dati in mobilità, dal 2013 è disponibile la APP per dispositivi Android e iOS
Potrebbero interessarti anche
FAQ - Balneazione
Balneazione
Qualità delle acque di balneazione
Balneazione
Cosa fa ARPAT
Balneazione
